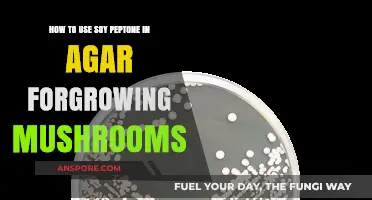
Using Soy Peptone in Agar: A Guide to Growing Mushrooms

Steel mushroom drywall anchors are innovative fasteners designed to securely attach objects to drywall without the need for wall studs. These anchors feature a unique mushroom-shaped head that expands upon insertion, creating a tight grip within the drywall cavity. Ideal for hanging lightweight to medium-weight items like shelves, mirrors, or picture frames, they are easy to install and provide reliable support. To use them, simply drill a pilot hole in the drywall, insert the anchor, and then screw in the provided screw until the mushroom head expands, ensuring a stable hold. This method minimizes wall damage and is a practical solution for walls where traditional stud mounting is not feasible.
Explore related products
What You'll Learn
- Pre-drilling Holes: Mark stud locations, use appropriate drill bit size to avoid drywall damage
- Screw Placement: Insert steel mushrooms evenly, ensuring tight fit without over-tightening screws
- Wall Alignment: Use level and plumb tools to maintain straight and vertical drywall installation
- Seam Taping: Apply joint tape and compound over seams for smooth, crack-free surface finish
- Finishing Tips: Sand lightly after compound dries, prime, and paint for professional-looking drywall completion

Pre-drilling Holes: Mark stud locations, use appropriate drill bit size to avoid drywall damage
Pre-drilling holes is a critical step when working with steel mushroom drywall anchors, ensuring a secure installation without compromising the integrity of the drywall. The process begins with accurately marking the stud locations, a task that demands precision. Use a stud finder to identify the wooden or metal studs behind the drywall, as these provide the strongest support for your anchors. Mark these spots with a pencil, ensuring the marks are clear but gentle to avoid damaging the drywall surface. This initial step sets the foundation for a successful installation, preventing the common mistake of drilling into weak spots that can lead to anchor failure.
Once the stud locations are marked, selecting the appropriate drill bit size becomes paramount. The drill bit should match the diameter of the steel mushroom anchor’s shaft, typically ranging from 3/16 to 1/4 inch, depending on the anchor model. Using a bit that’s too large can cause the drywall to crack or crumble around the hole, while a bit that’s too small may prevent the anchor from seating properly. A common rule of thumb is to choose a bit that’s slightly smaller than the anchor’s shaft, allowing the drywall to compress slightly as the anchor is inserted. This ensures a snug fit without excessive force that could damage the material.
The act of pre-drilling itself requires a steady hand and the right technique. Set your drill to low speed to maintain control and prevent overheating, which can weaken the drywall. Apply gentle, consistent pressure as you drill, stopping as soon as you penetrate the drywall. Avoid over-drilling into the stud, as this can split the wood or damage the anchor’s threading mechanism. For thicker drywall or double-layered installations, consider using a depth stop on your drill to ensure uniformity across multiple holes. This precision not only protects the drywall but also ensures the anchor expands correctly within the stud for maximum holding power.
A practical tip for beginners is to practice on a scrap piece of drywall before tackling the actual installation. This allows you to familiarize yourself with the drill’s speed, pressure, and the feel of breaking through the drywall. Additionally, using masking tape over the drilling spot can help prevent the bit from tearing the paper surface of the drywall, a common issue when drilling into softer materials. By combining careful marking, proper bit selection, and controlled drilling, pre-drilling holes for steel mushroom drywall anchors becomes a straightforward task that enhances both the durability and aesthetics of your installation.
Effective Mushroom Drying: Using Damprid for Optimal Results
You may want to see also

Screw Placement: Insert steel mushrooms evenly, ensuring tight fit without over-tightening screws
Steel mushrooms, when used in drywall applications, rely heavily on precise screw placement for structural integrity and aesthetic appeal. The key lies in achieving a balance: a tight fit that secures the mushroom without over-tightening, which can compromise the drywall or the mushroom itself. Start by marking the screw locations at consistent intervals, typically every 6 to 8 inches along the studs. This even distribution ensures the load is evenly spread, reducing the risk of warping or cracking. Use a level or straightedge to align the marks, ensuring a professional finish.
Over-tightening screws is a common pitfall that can lead to stripped threads, damaged drywall paper, or even cracked mushrooms. To avoid this, apply firm, consistent pressure until the screw head sits flush with the mushroom’s surface. A clutch-equipped drill or manual screwdriver with a torque-limiting feature can help prevent excessive force. If using a power drill, pause periodically to assess the fit, especially when nearing the final turns. Remember, the goal is to secure, not to force.
The interaction between the screw and the steel mushroom is critical. Ensure the screw threads engage fully with the mushroom’s pre-drilled holes, creating a mechanical bond that enhances stability. If the fit feels loose or the screw doesn’t catch, reevaluate the alignment or consider using a slightly larger screw size. Conversely, if the screw requires excessive force to turn, back it out and re-drill the hole to avoid damaging the mushroom or drywall. Precision at this stage pays dividends in the long-term durability of the installation.
For optimal results, pair the steel mushrooms with screws specifically designed for metal-to-drywall applications, such as self-tapping screws with coarse threads. These screws provide better grip and reduce the risk of over-tightening. Additionally, pre-drilling pilot holes in the drywall can minimize stress on the material, though this step is often unnecessary with self-tapping screws. Finally, inspect each screw after placement, ensuring uniformity and addressing any inconsistencies immediately. This meticulous approach ensures a secure, professional installation that stands the test of time.
Mastering Codes in Legend of Mushroom: Tips and Tricks
You may want to see also

Wall Alignment: Use level and plumb tools to maintain straight and vertical drywall installation
Achieving flawless wall alignment is the cornerstone of professional drywall installation, and it hinges on the precise use of levels and plumb tools. These instruments are not mere accessories; they are the arbiters of straightness and verticality, ensuring that every sheet of drywall contributes to a seamless, cohesive surface. Without them, even the most meticulously planned project risks visible imperfections that mar the final appearance.
Consider the level, a tool that embodies the principle of equilibrium. When installing drywall, a level becomes your trusted ally in verifying horizontal alignment. For standard 4x8 sheets, a 48-inch level is ideal, allowing you to check both the top and bottom edges simultaneously. Place the level along the seam where two sheets meet, adjusting until the bubble rests perfectly between the lines. This simple act prevents the compounding of errors, as even a slight misalignment at one joint can cascade into noticeable gaps or uneven surfaces by the time you reach the end of the wall.
Plumb tools, on the other hand, ensure vertical integrity. A plumb bob or laser plumb line is indispensable for confirming that your drywall sheets are perfectly perpendicular to the floor and ceiling. Start by anchoring the plumb bob at the ceiling, allowing it to hang freely. Align the edge of the drywall sheet with the plumb line, securing it in place before fastening. This method eliminates the risk of walls leaning inward or outward, a flaw that becomes glaringly obvious once trim or molding is installed.
For those working with steel mushroom drywall anchors, precision in alignment is even more critical. These anchors rely on accurate placement to distribute weight evenly and maintain structural integrity. Misaligned drywall can compromise the effectiveness of the anchors, leading to sagging or detachment over time. Always double-check alignment before inserting anchors, ensuring the drywall is both level and plumb to maximize their holding power.
In practice, combine these tools with a systematic approach. Begin by marking reference lines on the floor and ceiling using a chalk line, ensuring they are perfectly vertical. Use these lines as guides when positioning the first sheet of drywall, verifying alignment with both level and plumb tools. Repeat this process for each subsequent sheet, maintaining consistency across the entire installation. This methodical approach not only guarantees professional results but also streamlines the process, reducing the need for time-consuming corrections later.
Medicinal Mushrooms in Japan: Ancient Traditions and Modern Wellness Practices
You may want to see also
Explore related products

Seam Taping: Apply joint tape and compound over seams for smooth, crack-free surface finish
Seam taping is a critical step in achieving a professional, crack-free finish when working with steel mushroom drywall. Unlike traditional drywall, the unique profile of steel mushroom panels requires precise application of joint tape and compound to ensure seams remain invisible under paint or texture. Skipping this step or executing it poorly can result in visible lines, cracks, or even structural weaknesses over time.
Seam taping begins with selecting the right materials. Fiberglass mesh tape is generally preferred over paper tape for its flexibility and resistance to cracking, especially when paired with the rigid steel mushroom panels. All-purpose joint compound, mixed to a smooth, creamy consistency, is ideal for embedding the tape and filling seams. Apply a thin layer of compound along the seam using a 6-inch taping knife, ensuring even coverage without excess buildup.
Embedding the tape requires a delicate touch. Center the mesh tape over the seam, gently pressing it into the compound with the taping knife. Avoid stretching the tape, as this can lead to wrinkles or weak spots. Use the knife to smooth the tape, removing any air bubbles and ensuring it adheres firmly to the drywall. Allow the first coat to dry completely, typically 24 hours, before applying a second, slightly wider layer of compound to further conceal the seam.
Sanding between coats is essential for a flawless finish. Use a fine-grit sanding sponge or pole sander to smooth the dried compound, taking care not to damage the tape or surrounding drywall. Wipe away dust with a damp cloth before applying the next coat. For heavily trafficked areas or high-moisture environments, consider applying a third coat for added durability.
While seam taping may seem straightforward, common mistakes can compromise the final result. Applying too much compound at once can lead to cracking or shrinkage, while insufficient compound leaves seams visible. Rushing the drying process between coats can also cause cracks or delamination. Patience and attention to detail are key. For best results, maintain a consistent room temperature and humidity level during the drying process, and avoid overworking the compound once it begins to set. With proper technique and materials, seam taping transforms steel mushroom drywall seams from potential weaknesses into virtually invisible joints, ensuring a smooth, professional finish that lasts.
Enhance Your Risotto with Dried Mushrooms: A Flavorful Guide
You may want to see also

Finishing Tips: Sand lightly after compound dries, prime, and paint for professional-looking drywall completion
Achieving a seamless, professional finish on steel mushroom drywall hinges on meticulous attention to the final steps. Once the joint compound has fully dried—typically 24 hours depending on humidity and thickness—lightly sanding the area is crucial. Use 120- to 150-grit sandpaper to smooth out ridges and imperfections without damaging the paper surface. Over-sanding can expose the drywall tape or steel mushroom fasteners, so work gently and inspect frequently. This step ensures a flat, even surface ready for priming.
Priming is non-negotiable for a polished result. Choose a high-quality, drywall-specific primer to seal the compound and create a uniform base for paint. Apply one thin, even coat with a roller or brush, allowing it to dry completely—usually 2 to 4 hours. Primer not only enhances paint adhesion but also minimizes the number of paint coats needed, saving time and material. Skip this step, and you risk uneven color absorption and visible seams.
Painting is where your drywall truly transforms. Select a paint formulated for interior walls, and opt for a satin or eggshell finish for durability and subtle sheen. Apply the first coat using a roller for large areas and a brush for edges. Allow it to dry fully before assessing the need for a second coat. Pro tip: Add a small amount of paint conditioner to reduce brush marks and improve flow, especially in high-humidity environments.
Comparing the finished product to untreated drywall highlights the importance of these steps. Unprimed, unpainted drywall appears dull and uneven, with joints and fasteners often visible. In contrast, properly finished steel mushroom drywall boasts a smooth, cohesive surface that blends seamlessly with adjacent walls. The difference lies in the details—sanding, priming, and painting—each step building toward a professional-grade result.
For those tackling steel mushroom drywall for the first time, patience is key. Rushing the drying process or skipping sanding can lead to visible flaws. Invest in quality tools—a pole sander, premium primer, and angled brush—to streamline the process. Remember, the goal isn’t just to cover the drywall but to create a surface that looks and feels flawless. With these finishing tips, even novice DIYers can achieve results that rival those of seasoned professionals.
Vodka Extraction of Psilocin: Does It Remove Mushroom Contaminants?
You may want to see also
Frequently asked questions
Steel mushroom drywall, also known as steel stud drywall, uses steel framing instead of wood. It is more resistant to fire, moisture, and pests compared to traditional wood-framed drywall, making it ideal for commercial or high-moisture areas.
To install, first secure the steel studs to the floor, ceiling, and walls. Then, attach the drywall panels to the studs using screws designed for metal framing. Ensure proper spacing and alignment for a seamless finish.
Yes, steel mushroom drywall is suitable for high-humidity areas because steel is resistant to moisture and mold. Pair it with moisture-resistant drywall panels for best results.
Essential tools include a drill with metal-specific screws, a utility knife, a tape measure, a level, and a drywall saw. Additionally, use self-drilling screws to avoid pre-drilling holes in the steel studs.